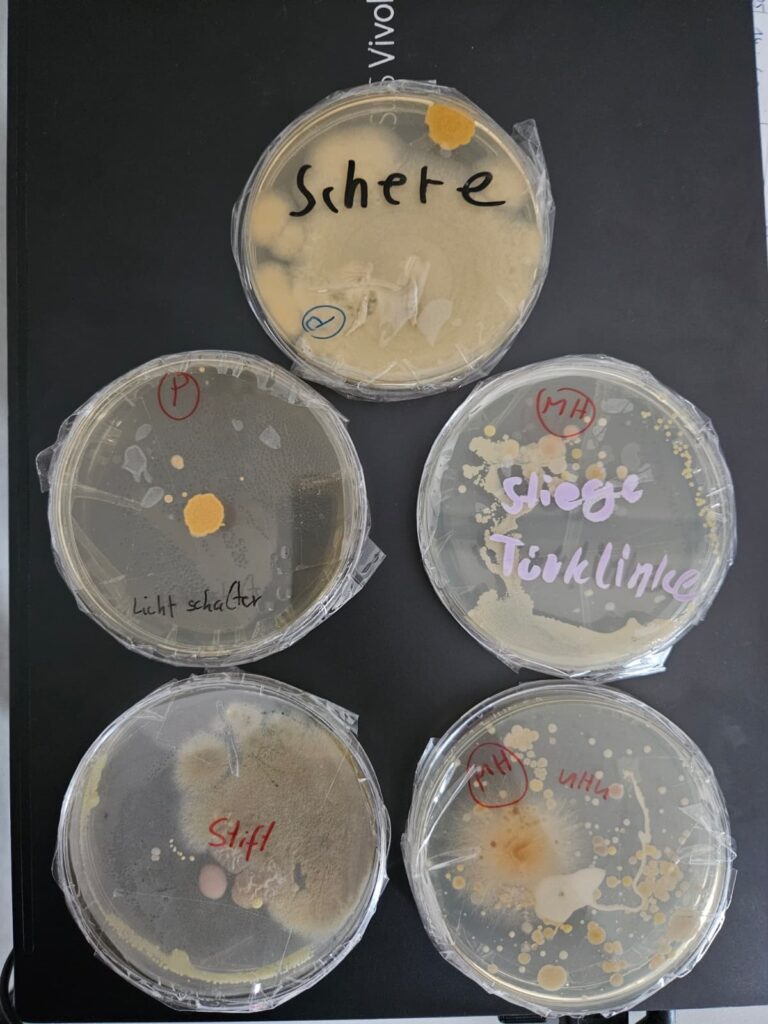
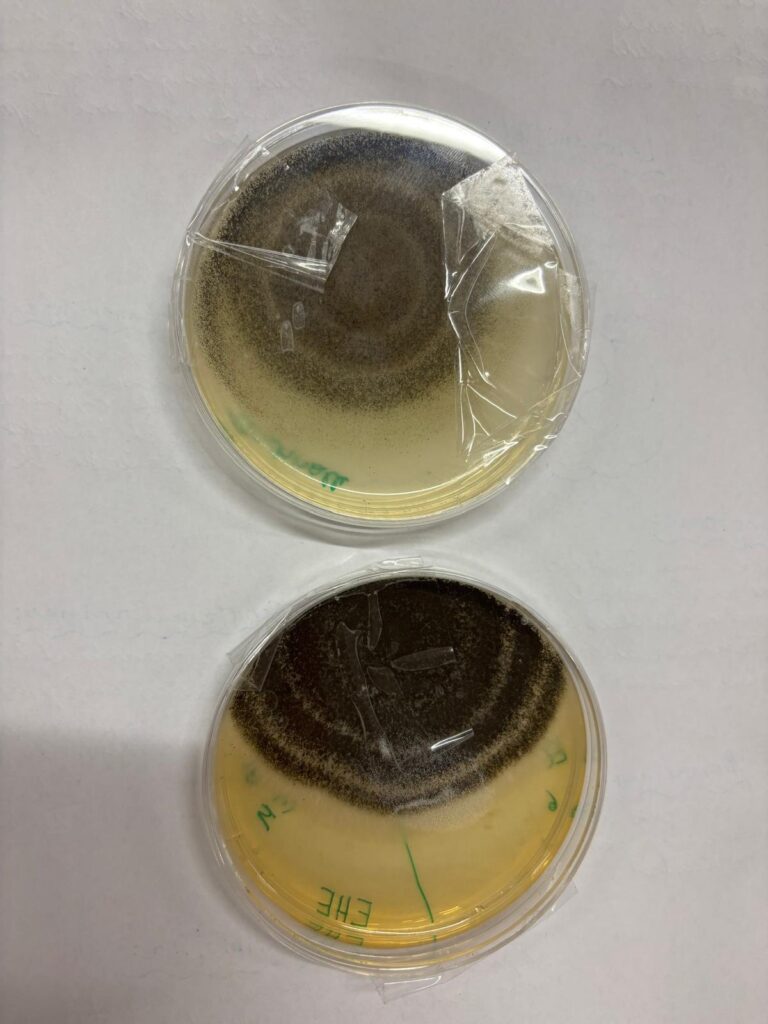
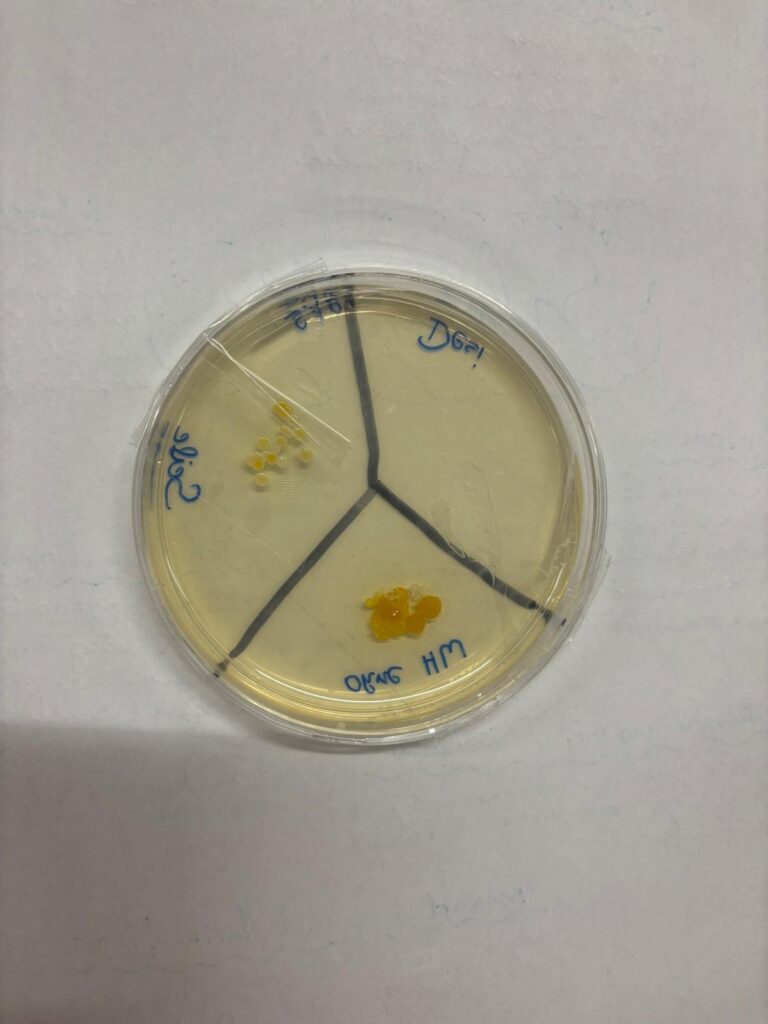

In der 2A und der 2M gingen die Schüler*innen der Frage nach, wie viele Mikroorganismen in unserer Umgebung oder sogar auf uns leben.
Dabei wurden unter anderem Proben von verschiedenen Gegenständen entnommen. So zeigte sich, dass so mancher Pilz auf einer Schere oder Türschnalle zuhause ist. Aber auch in der bloßen Luft fand sich so manches Bakterium.
Darüber hinaus wurde untersucht, wie sich Mikroorganismen durch Berührung übertragen. Selbst nach dem fünften Händedruck fanden sich noch übertragene Mikroorganismen. Daher wurde auch gleich die Wirksamkeit von Mundspülung, Seife und Desinfektionsmittel untersucht. So lernten die Schüler*innen, dass wir ständig von einer Vielzahl an Lebewesen umgeben sind – auch wenn wir sie nicht sehen können.